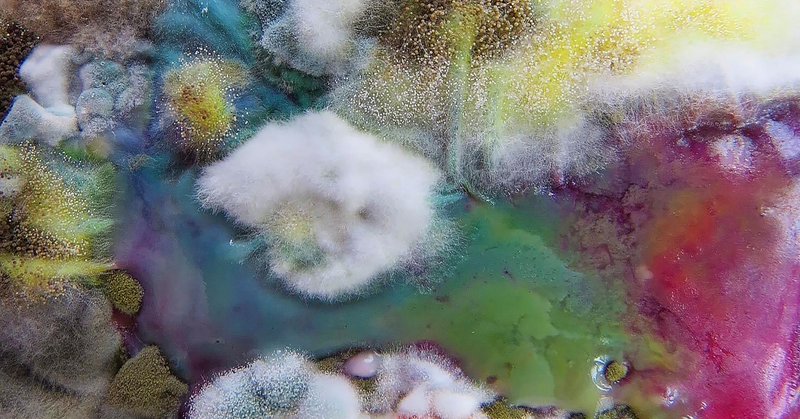
Tweet card summary image

Atmos
@AtmosMag
Followers
8K
Following
2K
Media
153
Statuses
3K
Climate and culture, inspired by nature. Magazine, features, newsletters, and more.
Planet Earth
Joined April 2019
With a ceasefire deal in Gaza, anti-Zionist Israeli writer Ita Segev pens a powerful call for honest reflection and collective action against oppression and genocide. @AtmosMag
https://t.co/XAKUpxXgeT
atmos.earth
With a ceasefire deal in Gaza, anti-Zionist Israeli writer Ita Segev pens a powerful call for honest reflection and collective action.
0
2
5
olive trees are at the center of Palestinian culture, but Israeli settler violence has seriously challenged them and their farmers for @AtmosMag, @PalomaDinechin visited olive growers in the West Bank to see how they're facing this existential threat https://t.co/zWya6BwxP0
atmos.earth
As Israeli settler violence intensifies in the West Bank, the annual harvest of olive trees is becoming less profitable—and less safe.
0
3
13
are plants smart? conscious, even? and should they be treated as legal persons? @romany_williams digs into botany's most contentious debate with @zoeschlanger, author of the new book, The Light Eaters, for @AtmosMag: https://t.co/zOjNoCjkRz
atmos.earth
Zoë Schlanger, author of the new book, The Light Eaters: How the Unseen World of Plant Intelligence Offers a New Understanding of Life on Earth, speaks to Atmos about the awe-inspiring findings of...
0
9
18
SCOOP: the Māori King and other Indigenous leaders will gather tomorrow to sign a treaty recognizing whales as legal persons. the movement is rooted in the Māori worldview, which sees whales as ancestors, one Māori conservationist writes for @AtmosMag:
atmos.earth
A Māori conservationist takes us inside the fight to recognize whales as legal persons and ocean ambassadors to the United Nations.
25
1K
4K
Hey friends! We're going to stop investing our energy into Twitter for the time-being and focus on having conversations and creating community on our other platforms—namely Instagram, TikTok, and now Threads! Click the link below to follow 🌱 https://t.co/FDF4YCPKVE
threads.com
61.3K Followers • 0 Threads • Climate and culture, inspired by nature 🌍 Magazine, podcast, newsletters, features, and more 🌱. See the latest conversations with @atmos.
0
0
7
Decades of violence and discrimination resulted in the loss of nearly all Black-owned farmland. Today, women of color are reclaiming their right to land stewardship. https://t.co/UmXltqqvPN
atmos.earth
Black farmers are reclaiming their right to land stewardship.
0
8
15
Climate change could put hummingbirds on an escalator to extinction, en route to a habitat that simply doesn’t exist. @JasonPDinh writes about the evolutionary wonders of the hummingbird. https://t.co/g8PSCzvX2G
atmos.earth
Leveraging both force and finesse, a new study shows how hummingbirds straddle contradictions in their quest for nectar.
0
5
4
Conservation dogs is all we need to know about today 🥹 Words by @michelechollow
https://t.co/zadZoZZozw
0
0
5
What’s lost when we capitalize on nostalgia? Route-66 became a tourist destination after the migration of the Dust Bowl Crisis died down, and is today home to many ghost towns. For Atmos, @lianademasi took a journey along its past and future. https://t.co/W4Q607r0CK
atmos.earth
Many of the stops along Route-66 are now ghost towns. If we don’t preserve our history in all its complexity, we’re bound to lose much more.
0
1
4
In Diné tradition, one rises each morning with the sun, blessing and greeting the day. How, in a modern world that encourages disconnection, can we honor synchronicity with nature? A poem by @KinsaleDrake
https://t.co/9BIyADwEFb
atmos.earth
Kinsale Drake explores how we can honor synchronicity with nature.
0
0
4
Canada is on fire. Meanwhile, Norway is going ahead with 19 new oil drilling projects, Biden approved Willow, and Trudeau ramps up fracking. Global leaders are approving fossil fuel expansions that will add gas to the fire.
430
928
2K
Decomposition is inevitable, whether it be within nature or within our human societies. In this week's edition of The Overview, @Willwrights asks: How can we learn to view waste as a possibility for wholeness? https://t.co/XlEaHTvzmj
atmos.earth
Decomposition is inevitable, whether it be within nature or within our human societies. How can we view it as an opportunity for wholeness?
0
2
8
Variation is the hallmark of evolution. This is especially true where sex and gender are concerned. In this edition of The Overview, @Willwrights looks at the many ways nature challenges binary thinking when it comes to sex. https://t.co/hfvjPq8xzF
atmos.earth
What does it mean to be female? Historically, the answer to this question has been defined by male scientists—but nature offers another view
0
0
1
Carbon colonialism is the system by which the Global North “outsources” carbon emissions by moving dirty industry and waste to the Global South. It's time for the Global North to start taking responsibility for its economy and its production. https://t.co/R2EO0bKzwA
atmos.earth
Carbon colonialism is a system where the Global North “outsources” carbon emissions by moving dirty industry and waste to the Global South.
0
6
8
Photographer Jermain Cikic turns his lens on Cuba’s bustling cities and sprawling landscapes, reflecting the country’s resilience and resourcefulness in the face of financial crisis. https://t.co/Ax1WDhpaKN
atmos.earth
Photographer Jermain Cikic turns his lens on Cuba’s bustling cities and sprawling landscapes.
0
1
3
Over the past 20 years, more than 100 million ash trees have died. In the Northeast, tribes are coming together to save the threatened black ash tree, a cultural treasure and ecological jewel, from a ravenous beetle. Words by @yessfun
https://t.co/uvwIiAtIx0
atmos.earth
In the Northeast, tribes are coming together to save the threatened black ash tree from a ravenous beetle.
0
2
9